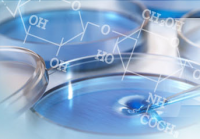

TheFact China | 2018/09/07 13:32
![]() |
JEJUON这个牌子在算是韩国本土小众牌子了
在中国几乎看不到它的影子
不过不能代表这并不好用
我们就是要善于挖掘好物分享给大家
给大家多一个选择~

品牌创始人是韩国化妆品领军人物
姜柳安院长
从事化妆品研究33年
还创立了韩国第一个化妆品专业(韩国淑民大学)
专注于有机天然化妆品研发的专业教授


今天要介绍的是它们家的郁金焕颜滋润系列面膜
注意啦,这里的郁金不是代表郁金香
郁金是一种中药材的名字
JEJUON在济州岛有自己的农场
在清净环境与火山灰土壤中亲自栽培的郁金
它含有各种维生素和抗氧化物质之神神经酰胺
对面斑、粉刺有很大帮助

多项实力认证

乐活认证纯棉100%无漂白面膜布!
根据国际性接触性皮肤皮炎研究会(ICDRG)的评价标准判定为无刺激性产品
原原本本的天然棉花籽!
郁金焕颜滋润山茶花面膜
![]() |
![]() |
含有大量茶素及维生素C,对皮肤细胞有强化保护作用
促进胶原蛋白形成,预防肌肤老化
山茶籽含有维生素A等细胞所需脂肪酸,预防皮肤干燥
郁金焕颜滋润油菜蜜面膜


含有给肌肤带来高保湿水分能量的油菜花蜜
油菜花蜜可令皮肤紧致,皱纹减少
还可增强代谢力,使皮肤组织细胞排列整齐
郁金焕颜滋润柑橘面膜


含有济州柑橘丰富的VC成分,强化皮质
提亮肤色,阻挡黑色素生成物质
郁金焕颜滋润香菇面膜


含有植物性雌性激素的香菇,帮
助皮肤光彩透亮
含有丰富的维他命D,强化皮肤免疫力
郁金焕颜滋润麦芽面膜


减少黑色素生成,透亮肌肤
含有麦芽蛋白质成分,增强皮肤弹力
郁金焕颜滋润透明质酸面膜

含有超高保湿成分的透明质酸
解决被外界损伤的皮肤问题
郁金焕颜滋润透蜗牛面膜


含有吃沙参长大的蜗牛粘液,增强皮肤弹力和保湿力
郁金焕颜滋润透海藻面膜


含有甘苔的海洋多酚 有效抗老化
来自济州岛丰富的褐藻酸 补充流失水分
